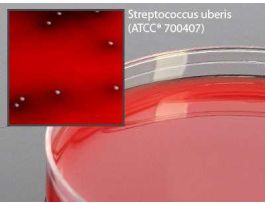
PLT TSA W BLD ESCULIN PK100
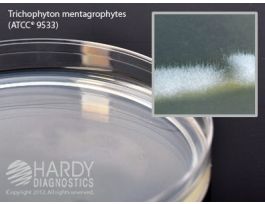
POTATO DEXTROSE AGAR PK100

Need Help?
800-229-7252
Lab Equipment
-
Rapid Bacterial Test Kit, Staphylococcus, rabbit plasma coagulase, 6 X 3 mL/kitEW-36151-10CPEW-36151-10-EA